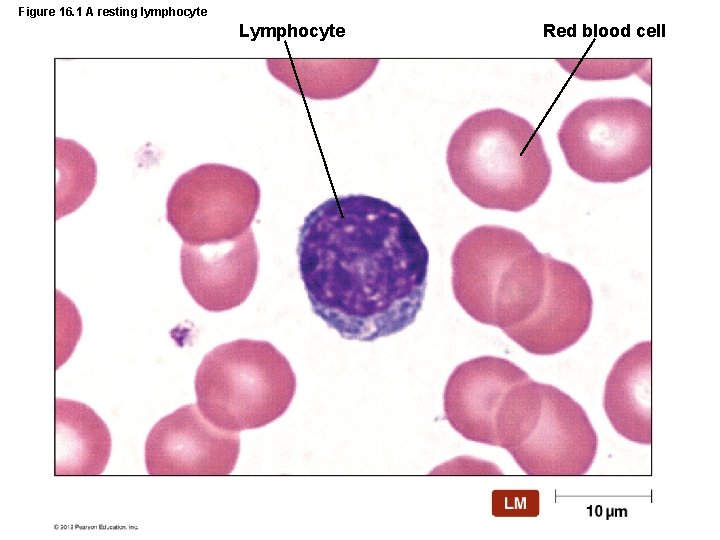

Adaptive Immunity Overview of Adaptive Immunity Adaptive immunity






















































- Slides: 54

Adaptive Immunity

Overview of Adaptive Immunity • Adaptive immunity is the body’s ability to recognize and defend itself against distinct invaders and their products • Five attributes of adaptive immunity – Specificity – Inducibility – Clonality – Unresponsiveness to self – Memory © 2012 Pearson Education Inc.

Overview of Adaptive Immunity • Involves activity of lymphocytes • Two main types of lymphocytes – B lymphocytes (B cells) • Mature in the bone marrow – T lymphocytes (T cells) • Mature in the thymus • Two types of adaptive immune responses – Humoral immune responses – Cell-mediated immune responses © 2012 Pearson Education Inc.
Figure 16. 1 A resting lymphocyte Lymphocyte Red blood cell

Elements of Adaptive Immunity • The Tissues and Organs of the Lymphatic System – Screen the tissues of the body foreign antigens – Composed of lymphatic vessels and lymphatic cells, tissues, and organs © 2012 Pearson Education Inc.

Elements of Adaptive Immunity • The Tissues and Organs of the Lymphatic System – Lymphatic vessels and the flow of lymph • Conducts lymph from tissues and returns it to the circulatory system – Lymph » Liquid with similar composition to blood plasma » Arises from fluid leaked from blood vessels into surrounding tissues © 2012 Pearson Education Inc.

Figure 16. 2 The lymphatic system-overview

Elements of Adaptive Immunity • The Tissues and Organs of the Lymphatic System – Lymphoid organs • Primary lymphoid organs – Red bone marrow – Thymus • Secondary lymphoid organs – Lymph nodes – Spleen – Tonsils – Mucosa-associated lymphatic tissue (MALT) © 2012 Pearson Education Inc.

Elements of Adaptive Immunity • Antigens – Properties of antigens • Molecules the body recognizes as foreign and worthy of attack • Recognized by three-dimensional regions called epitopes • Include various bacterial components as well as proteins of viruses, fungi, and protozoa • Food and dust can also contain antigenic particles © 2012 Pearson Education Inc.

Figure 16. 3 a Antigens: epitopes (antigenic determinants) Epitopes (antigenic determinants) Cytoplasmic membrane Nucleus Antigen Epitopes (antigenic determinants) Cytoplasm

Figure 16. 3 b Antigens: exogenous antigens Extracellular microbes Exogenous antigens

Figure 16. 3 c Antigens: endogenous antigens Endogenous antigens Intracellular virus Virally infected cell Endogenous antigens

Figure 16. 3 d Antigens: autoantigens Autoantigens (normal cell antigens) Normal (uninfected) cell Autoantigens

Elements of Adaptive Immunity • B Lymphocytes (B Cells) and Antibodies – Arise and mature in the red bone marrow – Found primarily in the spleen, lymph nodes, and MALT – Small percentage of B cells circulates in the blood – Major function is the secretion of antibodies © 2012 Pearson Education Inc.

Elements of Adaptive Immunity • B Lymphocytes (B Cells) and Antibodies – Specificity of the B cell receptor (BCR) • Each B lymphocyte has multiple copies of the B cell receptor • Each B cell generates a single BCR • Two variable regions of the BCR form the antigenbinding sites • Each BCR recognizes only one epitope • Individual’s repertoire of BCRs is capable of recognizing millions of different epitopes © 2012 Pearson Education Inc.

Figure 16. 4 B cell receptor (BCR) Epitope Heavy chain Antigenbinding sites Variable region Light chain Cytoplasmic membrane of B lymphocyte Transmembrane portion of BCR B cell receptor (BCR) Cytoplasm

Elements of Adaptive Immunity • B Lymphocytes (B Cells) and Antibodies – Specificity and antibody structure • Antibodies are immunoglobulins similar to BCRs • Secreted by activated B cells called plasma cells • Identical antigen-binding sites and antigen specificity as the BCR of the activated B cell © 2012 Pearson Education Inc.

Figure 16. 5 Basic antibody structure-overview

Elements of Adaptive Immunity • B Lymphocytes (B Cells) and Antibodies • Antibody function – Antigen-binding sites are complementary to epitopes – Antibodies function in several ways • • • Activation of complement and inflammation Neutralization Opsonization Killing by oxidation Agglutination Antibody-dependent cellular cytotoxicity (ADCC) © 2012 Pearson Education Inc.

Figure 16. 6 Five functions of antibodies-overview

Elements of Adaptive Immunity • B Lymphocytes (B Cells) and Antibodies – Classes of antibodies • Threats confronting the immune system are variable • Class involved in the immune response depends on the type of antigen, portal of entry, and antibody function needed • Five different classes of antibodies © 2012 Pearson Education Inc.

Elements of Adaptive Immunity • B Lymphocytes (B Cells) and Antibodies – Classes of antibodies • • Ig. M–first antibody produced Ig. G–most common and longest-lasting antibody Ig. A–associated with body secretions Ig. E–involved in response to parasitic infections and allergies • Ig. D–exact function is not known © 2012 Pearson Education Inc.

Elements of Adaptive Immunity • T Lymphocytes (T Cells) – Produced in the red bone marrow and mature in the thymus – Circulate in the lymph and blood and migrate to the lymph nodes, spleen, and Peyer’s patches – Antigen-binding sites are complementary to epitopes – Have T cell receptors (TCRs) on their cytoplasmic membrane © 2012 Pearson Education Inc.

Elements of Adaptive Immunity • T Lymphocytes – Specificity of the T cell receptor (TCR) • TCRs do not recognize epitopes directly • TCRs only bind epitopes associated with a MHC protein • TCRs act primarily against cells that harbor intracellular pathogens © 2012 Pearson Education Inc.

Figure 16. 7 A T cell receptor (TCR) Antigen-binding site (groove) Carbohydrate Variable regions Disulfide bond Constant regions Cytoplasmic membrane of T cell receptor (TCR) Cytoplasm

Elements of Adaptive Immunity • T Lymphocytes – Types of T lymphocytes • Based on surface glycoproteins and characteristic functions • Three types – Cytotoxic T lymphocyte » Directly kills other cells – Helper T lymphocyte » Helps regulate the activities of B cells and cytotoxic T cells – Regulatory T lymphocyte » Represses adaptive immune responses © 2012 Pearson Education Inc.

Elements of Adaptive Immunity • Clonal Deletion – Vital that immune responses not be directed against autoantigens – Body eliminates self-reactive lymphocytes – Lymphocytes that react to autoantigens undergo apoptosis © 2012 Pearson Education Inc.

Figure 16. 8 Clonal deletion of T cells Stem cell (in red bone marrow) T cells TCRs MHC I Epitope Recognize MHC I? Thymus cells Yes No Receive survival signal Recognize MHC-autoantigen? Apoptosis Yes No Few Most Apoptosis Repertoire of immature Tc cells Regulartoy T cell (Tr)

Figure 16. 9 Clonal deletion of B cells Stem cell (in red bone marrow) B cells BCRs Cell with autoantigens Apoptosis Blood vessel To spleen

Elements of Adaptive Immunity • Immune Response Cytokines – Soluble regulatory proteins that act as intercellular signals – Cytokines secreted by various leukocytes – Cytokine network • The complex web of signals among all the cells of the immune system © 2012 Pearson Education Inc.

Elements of Adaptive Immunity • Immune System Cytokines – Interleukins (ILs) • Signal among leukocytes – Interferons (IFNs) • Antiviral proteins that may act as cytokines – Growth factors • Proteins that stimulate stem cells to divide – Tumor necrosis factor (TNF) • Secreted by macrophages and T cells to kill tumor cells and regulate immune responses and inflammation – Chemokines • Chemotactic cytokines that signal leukocytes to move © 2012 Pearson Education Inc.

Preparation for an Adaptive Immune Response • The Roles of the Major Histocompatibility Complex – Group of antigens first identified in graft patients – Important in determining compatibility of tissues for tissue grafting – Major histocompatibility antigens are glycoproteins found in the membranes of most cells of vertebrate animals – Hold and position antigenic determinants for presentation to T cells © 2012 Pearson Education Inc.

Preparation for an Adaptive Immune Response • The Roles of the Major Histocompatibility Complex – Antigens bind in the antigen-binding groove of MHC molecules – Two classes of MHC proteins • MHC class II © 2012 Pearson Education Inc.

Figure 16. 10 The two classes of major histocompatibility complex (MHC) proteins Antigen-binding grooves Cytoplasmic membrane Class I MHC on every nucleated cell Class II MHC on B cell or other antigen-presenting cell (APC) Cytoplasm

Figure 16. 11 Dendritic cells Dendrites

Preparation for an Adaptive Immune Response • Antigen Processing – Antigens processed for MHC proteins to display epitopes – Different processes for endogenous and exogenous antigens © 2012 Pearson Education Inc.

Figure 16. 12 The processing of T-dependent endogenous antigens Polypeptide MHC I protein in membrane of endoplasmic reticulum Epitopes Lumen of endoplasmic reticulum The polypeptide is catabolized to yield epitopes, which are loaded onto complementary MHC I proteins in the ER. MHC I protein– epitope complex MHC I protein–epitope complexes are packaged in vesicle. Vesicle fuses with cytoplasmic membrane. MHC I protein– epitope complexes on cell surface Cytoplasmic membrane MHC I protein–epitope complexes displayed on cytoplasmic membranes of all nucleated cells

Figure 16. 13 The processing of T-dependent exogenous antigens Phagocytosis by APC Exogenous pathogen with antigens MHC II protein in membrane of vesicle Epitopes in phagolysosome MHC II protein– epitope complex Vesicles fuse and epitopes bind to complementary HHC II molecules. Vesicle fuses with cytoplasmic membrane. MHC II protein– epitope complexex on cell surface Cytoplasmic membrane MHC II protein–epitope complexes displayed on cytoplasmic membranes of antigen-presenting cell

Cell-Mediated Immune Responses • Respond to intracellular pathogens and abnormal body cells • The most common intracellular pathogens are viruses • The response is also effective against cancer cells, intracellular protozoa, and intracellular bacteria © 2012 Pearson Education Inc.

Cell-Mediated Immune Responses • Activation of T Cell Clones and Their Functions – Steps involved in activation of cytotoxic T cells • • Antigen presentation Helper T cell differentiation Clonal expansion Self-stimulation © 2012 Pearson Education Inc.

Figure 16. 14 Activation of a clone of cytotoxic T (Tc) cells Dendritic cell Antigen presentation MHC I CD 8 DC MHC II protein Epitope TCR Th cell Tc cell Inactive Tc cell IL-12 IL-2 receptor (IL-2 R) Th differentiation Immunological synapse IL-2 Th 1 cell Clonal expansion IL-2 R Memory T cell Active Tc cells IL-2 Self-stimulation Active Tc cells IL-2

Figure 16. 15 a A cell-mediated immune response: binding of virus-infected cell Active cytotoxic T (Tc) cell TCR Viral epitope MHC I protein Virally infected cell Intracellular virus CD 8

Figure 16. 15 b A cell-mediated immune response: perforin-granzyme cytotoxic pathway Tc cell Perforin Granzyme Perforin complex (pore) Granzymes activate apoptotic enzymes Inactive apoptotic enzymes Active apoptotic enzymes induce apoptosis Virally infected cell

Figure 16. 15 c A cell-mediated immune response: CD 95 cytotoxic pathway Tc cell CD 95 L CD 95 Enzymatic portion of CD 95 becomes active Inactive apoptotic enzymes Active apoptotic enzymes induce apoptosis Virally infected cell

Cell-Mediated Immune Responses • Memory T Cells – Some activated T cells become memory T cells – Persist for months or years in lymphoid tissues – Immediately functional upon subsequent contacts with epitope specific to its TCR © 2012 Pearson Education Inc.

Cell-Mediated Immune Responses • T Cell Regulation – Regulation needed to prevent T cell response to autoantigens – T cells require additional signals from an antigen-presenting cell • Interaction of the T cell and antigenpresenting cell stimulates the T cell to respond to the antigen © 2012 Pearson Education Inc.

Humoral Immune Responses • Humoral immune responses mounted against exogenous pathogens • Activates only in response to specific pathogens • Two types – T-independent humoral immunity – T-dependent humoral immunity © 2012 Pearson Education Inc.

Figure 16. 16 The effects of the binding of a T-independent antigen by a B cell Polysaccharide with repeating subunits BCRs B cell Plasma cells Antibodies

Figure 16. 17 A plasma cell Rough endoplasmic reticulum Nucleus Golgi body

Figure 16. 18 A T-dependent humoral immune response Repertoire of Th cells (CD 4 cells) Th cell CD 4 TCR CD 4 CD 28 Epitope CD 80 (or CD 86) MHC II TCRs APC presents antigen to Th cells for Th activation and cloning. APC Th cell differentiates into Th 2 cell. Th cell clones CCR 3 CCR 4 IL-4 Th 2 cell MHC II proteins Select clone of B cell. Th 2 cell TCR CD 40 L Epitope MHC II CD 40 IL-4 B cell Repertoire of B cells TH 2 cell activates B cell. BCR Clone of plasma cells Antibodies Memory B cells

Humoral Immune Responses • Inducement of T-Dependent Humoral Immunity – Plasma cells • Majority of cells produced during B cell proliferation • Only secrete antibody molecules complementary to the specific antigen • Short-lived cells that die within a few days of activation – Their antibodies and progeny can persist © 2012 Pearson Education Inc.

Humoral Immune Responses • Memory B Cells and the Establishment of Immunological Memory – Produced by B cell proliferation but do not secrete antibodies – Have BCRs complementary to the antigenic determinant that triggered their production – Long-lived cells that persist in the lymphoid tissue – Initiate antibody production if antigen is encountered again © 2012 Pearson Education Inc.

Figure 16. 19 The production of primary and secondary humoral immune responses--overview

Types of Acquired Immunity • Specific immunity acquired during an individual’s life • Two types – Naturally acquired • Response against antigens encountered in daily life – Artificially acquired • Response to antigens introduced via a vaccine • Distinguished as either active or passive – Active – Passive • Receive antibodies from another individual © 2012 Pearson Education Inc.